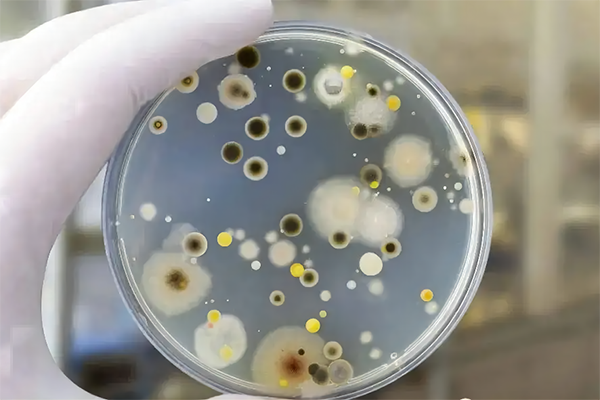
放霉检测

йңүиҸҢеңЁжё©жҡ–ж№ҝж¶Ұзҡ„жғ…еҪўдёӢ��пјҢжңүзқҖжһҒејәзҡ„ж»Ӣз”ҹиғҪеҠӣ��пјҢ并且ж»Ӣз”ҹж–№жі•д№ҹжҳҜеӨҡз§ҚеӨҡж ·зҡ„��пјҢе…¶зҲҶеҸ‘зҡ„жңүжҜ’д»Ји°ўзү©вҖ”вҖ•йңүиҸҢжҜ’зҙ еҜ№дәәе’Ңз•ңзҰҪдё»иҰҒжҜ’жҖ§дҪ“зҺ°еңЁзҘһз»Ҹе’ҢеҶ…жё—йҖҸжқӮд№ұгҖҒе…Қз–«жҠ‘еҲ¶гҖҒиҮҙзҷҢиҮҙз•ёгҖҒиӮқиӮҫжҚҹдјӨгҖҒж»Ӣз”ҹйҡңзўҚзӯү��гҖӮеӣ жӯӨе…ідәҺдә§е“Ғзҡ„е…·жңүйҳІйңүеҠҹж•Ҳзҡ„йңҖжұӮд№ҹи¶ҠжқҘи¶ҠеӨҡ��гҖӮ

йҳІйңүжЈҖжөӢе·Ҙе…·
1.ж¶Ӯж–ҷ
2.еЎ‘ж–ҷ/ж©Ўиғ¶
3.зәәз»Үе“Ғ/зҡ®йқ©
4.еҜҶе°Ғиғ¶
5.жңЁеҲ¶е“Ғ
6.йҷ¶з“·еҲ¶е“Ғ
7.еҢ…иЈ…дә§е“Ғ
8.з”өеӯҗдә§е“Ғ/иЈ…еӨҮзӯүзӯү
йҳІйңүжЈҖжөӢж ҮеҮҶ
йҳІйңүж ҮеҮҶеҲҶдёәеӣҪ家ж ҮеҮҶпјҲISOпјү��пјҢеӣҪ家ж ҮеҮҶпјҲGBгҖҒJISгҖҒASTMпјү��пјҢиЎҢдёҡж ҮеҮҶпјҲQBгҖҒHGгҖҒJCзӯүпјү��пјҢең°ж–№ж ҮеҮҶпјҲDBпјү��пјҢдјҒдёҡж ҮеҮҶпјҲQ/Lпјүзӯү��гҖӮ
ж¶Ӯж–ҷ/жјҶиҶңйҳІйңүжЈҖжөӢж ҮеҮҶпјҡ
жјҶиҶңиҖҗйңүиҸҢжөӢе®ҡжі•GB/T 1741-2007
жјҶиҶңеҸҠжңүе…іж¶ӮеұӮиҖҗйңүиҸҢжҚҹеқҸзҡ„ж ҮеҮҶиҜ•йӘҢиҰҒйўҶASTM D 5590-00 пјҲ2010пјү
жјҶиҶңиҖҗйңүиҸҢиҜ•йӘҢBS3900 пјҡ Part G6пјҡ 1989
жғ…еҪўжЁЎжӢҹе®ӨеҶ…ж¶ӮеұӮеӨ–иІҢзҡ„иҖҗйңүиҸҢз”ҹй•ҝж ҮеҮҶиҜ•йӘҢиҰҒйўҶASTM D3273-2012
еҢ…иЈ…дә§е“ҒйҳІйңүжЈҖжөӢж ҮеҮҶпјҡ
йҳІйңүеҢ…иЈ… GB/T 4768-2008
жҢҘеҸ‘жҖ§жЎЈжЎҲйҳІйңүеүӮйҳІйңүж•ҲжһңжөӢе®ҡжі•DA/T 26-2000
з”өеӯҗдә§е“Ғ/иЈ…еӨҮзұ»йҳІйңүжЈҖжөӢж ҮеҮҶпјҡ
иҲ№иҲ¶иЈ…еӨҮжғ…еҪўдёҲйҮҸиҰҒйўҶпјҡйңүиҸҢCB 1171.7-1987
ж°‘з”ЁйЈһжңәжңәиҪҪиЈ…еӨҮжғ…еҪўе’ҢиҜ•йӘҢиҰҒйўҶйңүиҸҢиҜ•йӘҢHR-6167.11-1989
е…үеӯҰе’Ңе…үеӯҰд»ӘеҷЁжғ…еҪўиҜ•йӘҢиҰҒйўҶ第11йғЁеҲҶпјҡй•ҝйңүGB/T 12085.11-2010
з”өе·Ҙз”өеӯҗдә§е“Ғжғ…еҪўиҜ•йӘҢ第в’үйғЁеҲҶпјҡиҜ•йӘҢиҰҒйўҶиҜ•йӘҢJе’ҢеҜјеҲҷпјҡй•ҝйңүGB/T2423.16-2008
еЎ‘ж–ҷ/ж©Ўиғ¶йҳІйңүжЈҖжөӢж ҮеҮҶпјҡ
еЎ‘ж–ҷ.еЎ‘ж–ҷжҲҗд»ҪдёӯжҠ‘еҲ¶зңҹиҸҢеҢ–еҗҲзү©зҡ„ж•ҲжһңиҜ„д»·ISO 16869-2008
еЎ‘ж–ҷеңЁзңҹиҸҢдҪңз”ЁдёӢзҡ„иЎҢдёәжөӢе®ҡISO 846пјҡ 1997
еЎ‘ж–ҷйҳІйңүжҖ§иғҪиҜ•йӘҢиҰҒйўҶGB/T 24128-2009
жҠ—иҸҢеЎ‘ж–ҷзҡ„жҠ—иҸҢжҖ§иғҪиҜ•йӘҢиҰҒйўҶQB/T 2591-2003
ж©Ўиғ¶йҳІйңүжҖ§иғҪжөӢиҜ•иҰҒйўҶHG/T 4301-2012
йқһйҮ‘еұһеһ«зүҮиҙЁж–ҷеҲҶзұ»зі»з»ҹеҸҠиҜ•йӘҢиҰҒйўҶ第11йғЁеҲҶеҗҲжҲҗиҒҡеҗҲиҙЁж–ҷжҠ—йңүжҖ§жөӢе®ҡиҰҒйўҶGB/T 20671.11-2006
еҗҲжҲҗй«ҳеҲҶеӯҗиҙЁж–ҷжҠ—зңҹиҸҢжҖ§иғҪзҡ„жөӢе®ҡASTM G21-13
дҝ®е»әз”ЁжҠ—иҸҢеЎ‘ж–ҷз®ЎжҠ—з»ҶиҸҢжҖ§иғҪJC/T 939-2004
еЎ‘ж–ҷе’ҢйқһеӨҡеӯ”еӨ–иІҢжҠ—иҸҢжҖ§иғҪжөӢе®ҡISO 22196пјҡ2011
иғ¶й»ҸеүӮйҳІйңүжЈҖжөӢж ҮеҮҶпјҡ
дҝ®е»әз”ЁйҳІйңүеҜҶе°Ғиғ¶JC/T 885-2001
еЈҒзәёиғ¶зІҳеүӮJC/T 548-94
зәәз»Үе“Ғ/зҡ®йқ©йҳІйңүжЈҖжөӢж ҮеҮҶпјҡ
зҡ®йқ©йҳІйңүжҖ§иғҪжөӢиҜ•иҰҒйўҶQB/T 4199-2011
зҡ®йқ©йҳІйңүжҖ§иғҪжөӢиҜ•иҰҒйўҶQB/T 4199-2011
жҠ—иҸҢиҒҡж°Ёй…ҜеҗҲжҲҗйқ©жҠ—иҸҢжҖ§иғҪиҜ•йӘҢиҰҒйўҶе’ҢжҠ—еҚ—QB/T 4341-2012
зәәз»Үе“ҒйҳІйңүжҖ§иғҪзҡ„иҜ„е®ҡGB/T24346-2009
家用зәәз»Үе“ҒйҳІйңүжҖ§иғҪжөӢиҜ•иҰҒйўҶFZ/T 60030-2009
и“қиүІиҙЁж–ҷпјҲзҡ®йқ©пјүжҠ—йңүиҸҢз”ҹй•ҝиҜ•йӘҢиҰҒйўҶASTM D4576 08пјҲ2013пјү
жңЁеҲ¶е“ҒйҳІйңүжЈҖжөӢж ҮеҮҶпјҡ
жҠ—иҸҢйҳІйңүжңЁиҙЁиЈ…йҘ°жқҝJC/T 2039-2010
жҠ—иҸҢж°ҙпјҲз«№пјүиҙЁең°жқҝжҠ—иҸҢжҖ§иғҪзЈЁз»ғиҰҒйўҶдёҺжҠ—иҸҢж•ҲжһңLYT 1926-2010
йҳІйңүеүӮеҜ№жңЁж–ҷйңүиҸҢеҸҠеҸҳиүІиҸҢйҳІжІ»ж•ҲеҠӣзҡ„иҜ•йӘҢиҰҒйўҶGB/T 18261-2013
йҷ¶з“·еҲ¶е“ҒйҳІйңүжЈҖжөӢж ҮеҮҶпјҡ
з»Ҷи…»йҷ¶з“·пјҲй«ҳзә§йҷ¶з“·��пјҢй«ҳзә§е·Ҙдёҡйҷ¶з“·пјү--еҚҠеҜјжҖ§е…үеӮ¬еҢ–иҙЁж–ҷжҠ—иҸҢжҙ»жҖ§зҡ„иҜ•йӘҢиҰҒйўҶ ISO 13125-2013
жҠ—иҸҢйҷ¶з“·еҲ¶е“ҒжҠ—иҸҢжҖ§иғҪJC/T897-2014
йҳІйңүжЈҖжөӢеёёи§ҒиҰҒйўҶ
1гҖҒжҺҘз§Қпјҡеҗ‘йңүиҸҢзҡ„е№ізҡҝдёӯеҜје…Ҙ 3-6mmзҡ„иҗҘе…»дҪңиӮІеҹә��пјҢдҪңиӮІеҹәеҮқеӣәеҗҺ��пјҢе°Ҷж ·е“Ғе®үжҺ’еңЁдҪңиӮІеҹәеӨ–иІҢ��гҖӮз”ЁзҒӯиҸҢеҗҺзҡ„е–·йӣҫеҷЁж··ж·ҶйңүиҸҢжҠұеӯҗжӮ¬жө®ж¶ІеҢҖз§°еҗ‘ж ·е“ҒеӨ–иІҢе–·жҙ’��пјҢдҪҝж··ж·ҶеӯўеӯҗжӮ¬жө®ж¶Іж¶Ұж№ҝж•ҙдёӘж ·е“ҒеӨ–иІҢ��гҖӮ
2гҖҒдҪңиӮІпјҡзӣ–еҘҪе·ІжҺҘз§Қзҡ„иҜ•йӘҢж ·е“Ғзҡ„е№ізҡҝ��пјҢзҪ®дәҺзӣёе®ңзҡ„жё©еәҰгҖҒж№ҝеәҰдёӢдҪңиӮІ��пјҢдҪңиӮІж—¶й—ҙдёә28d��пјҢиӢҘжҳҜзҹіжЈүеӨ–иІҢз”ҹй•ҝзҡ„йңүиҸҢиҝҮеӨҡ��пјҢжҠөиҫҫй«ҳе“Ғзә§��пјҢеҚіз»§з»ӯиҜ•йӘҢж— ж„Ҹд№ү��пјҢеҸҜд»Ҙе°‘дәҺ28d��пјҢжҠҘе‘ҠдёӯиҜҰиҝ°дҪңиӮІж—¶й—ҙ��гҖӮ
3гҖҒйңүиҸҢз”ҹй•ҝжғ…еҪўи§ҶеҜҹеҸҠиҜ„зә§пјҡе·®еҲ«ж ҮеҮҶзҡ„е“Ғзә§иҜ„еҲӨж ҮеҮҶжңүжүҖе·®еҲ«��гҖӮ

еҫ®дҝЎе’ЁиҜў
еҫ®дҝЎе’ЁиҜў дҝЎжҒҜжҸҗдәӨд№җжҲҗ
дҝЎжҒҜжҸҗдәӨд№җжҲҗ